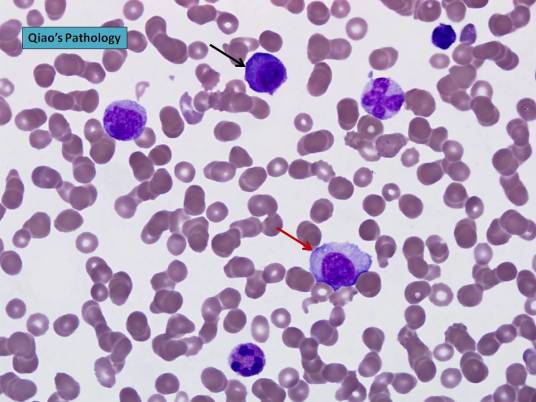
浆细胞

浆细胞
的有关信息介绍如下:
浆细胞(plasma cell),又称效应B细胞。浆细胞大多见于消化管和呼吸道固有膜的结缔组织内。细胞较小,圆形或卵圆形,核圆但偏于细胞一侧,染色质粗,沿核膜呈辐射状排列成车轮状。细胞质呈嗜碱性,染为蓝色。近细胞核处有一色较浅而透明的区域。电镜下可见细胞质内含大量密集的粗面内质网,浅染区是高尔基复合体所在的部位。浆细胞来源于B细胞。
想要了解更多“浆细胞”的信息,请点击:浆细胞百科
浆细胞(plasma cell),又称效应B细胞。浆细胞大多见于消化管和呼吸道固有膜的结缔组织内。细胞较小,圆形或卵圆形,核圆但偏于细胞一侧,染色质粗,沿核膜呈辐射状排列成车轮状。细胞质呈嗜碱性,染为蓝色。近细胞核处有一色较浅而透明的区域。电镜下可见细胞质内含大量密集的粗面内质网,浅染区是高尔基复合体所在的部位。浆细胞来源于B细胞。
想要了解更多“浆细胞”的信息,请点击:浆细胞百科